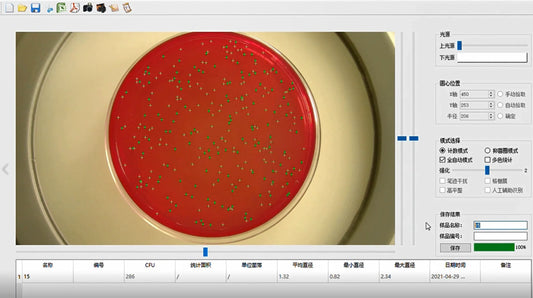

- Collection
- Products
Collection: Products
-
Automated Saturation Vapor Pressure Tester for Fast, Accurate Analysis of Gasoline & Volatile Crude Oils
Regular price From $86,000.00 USDRegular priceUnit price / per$105,000.00 USDSale price From $86,000.00 USDSALE -






Automatic Car AC Refrigerant Recovery & Gas Filling Machine - AC Flush System for Automotive
Regular price From $3,300.00 USDRegular priceUnit price / per$3,800.00 USDSale price From $3,300.00 USDSALE -
Automatic Chemical Dispenser for Acid Solutions | Laboratory Equipment
Regular price From $8,000.00 USDRegular priceUnit price / per$13,500.00 USDSale price From $8,000.00 USDSALE -



Automatic Coal Sulfur Meter | Leco Carbon Sulfur Analyzer | Sulfur Content Tester Machine I MBXTDL9A
Regular price From $5,500.00 USDRegular priceUnit price / per$5,967.50 USDSale price From $5,500.00 USDSALE -
Automatic Coin Counter High Speed Sorting Machine Clear Led Display Coin Money Counter
Regular price From $1,200.00 USDRegular priceUnit price / per$1,800.00 USDSale price From $1,200.00 USDSALE -
Automatic Digital Colony Counter – Smart Bacteria Counting Lab Equipment for Microbiology
Regular price $14,000.00 USDSale price $14,000.00 USDUnit price / per -
Automatic Foot & Ankle Exerciser | Electric Rehab Trainer for Elderly & Disabled
Regular price From $580.00 USDRegular priceUnit price / per$680.00 USDSale price From $580.00 USDSALE -
Automatic Honey Extraction I Honeycomb Uncapping Machine & Frame Uncapper I Model MUDGP200
Regular price From $8,500.00 USDRegular priceUnit price / per$8,900.00 USDSale price From $8,500.00 USDSALE -
Automatic Kinematic Viscosity Tester for Accurate Results I Rubber Mooney Viscometer DZ320
Regular price From $9,350.00 USDRegular priceUnit price / per$9,500.00 USDSale price From $9,350.00 USDSALE -




Automatic PLC-Controlled Water Spray Retort Sterilizer Autoclave Machine for Industrial Use
Regular price From $53,000.00 USDRegular priceUnit price / per$401,740.00 USDSale price From $53,000.00 USDSALE -
Automatic PPP Extractor Platelet Rich Plasma Extractor Machine I Meubon
Regular price From $5,200.00 USDRegular priceUnit price / per$5,400.00 USDSale price From $5,200.00 USDSALE -
Automatic Seeds Counter Machine – Microcomputer-Controlled for Various Seed Shapes, Blue with Clearance Adjustment Knob
Regular price From $780.00 USDRegular priceUnit price / per$799.00 USDSale price From $780.00 USDSALE -
Automatic sperm collector I Portable Medical High quality sperm collector
Regular price From $4,299.00 USDRegular priceUnit price / per$4,900.00 USDSale price From $4,299.00 USDSALE -
Automatic Strain Unconfined Compression Tester: Precise Testing for Structural Stability MV553322
Regular price $4,200.00 USDSale price $4,200.00 USDUnit price / per -
Automatic Ultrasound Bone Densitometer I MYB14MD
Regular price From $7,000.00 USDRegular priceUnit price / per$7,800.00 USDSale price From $7,000.00 USDSALE -
Automatic Viscometer Type: Kinematic Viscosity Meter for Precision Testing MIVS6002
Regular price From $70,000.00 USDRegular priceUnit price / per$75,000.00 USDSale price From $70,000.00 USDSALE -
B Mode Portable Laptop Veterinary Ultrasound Scanner For Cats Dogs I KX-5600V
Regular price $2,750.00 USDSale price $2,750.00 USDUnit price / per -
B71 Audiometer Bone Conductor Earphone Transducer Receiver
Regular price From $98.00 USDRegular priceUnit price / per$148.20 USDSale price From $98.00 USDSALE -
Baby Bath tub Large Portable Folding Collapsible Baby Bathtub
Regular price $149.00 USDSale price $149.00 USDUnit price / per -
Baby Play Mat Crawling Mat Soft EVA Foam Kids Playing Mat Floor Interlocking Mats
Regular price $27.00 USDSale price $27.00 USDUnit price / per